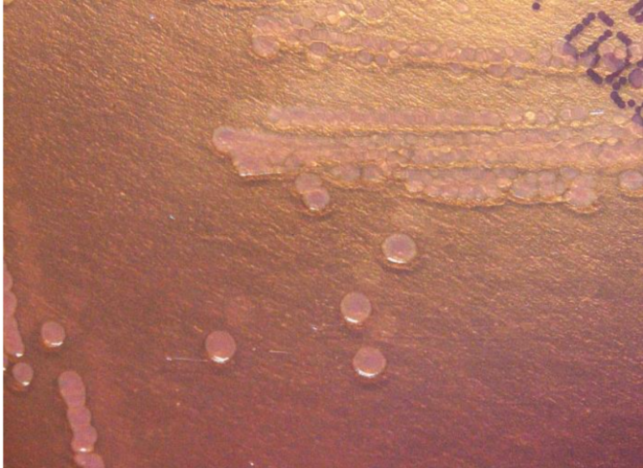

1.假结核耶尔森菌(Yersinia Pseudotuberculosis)
物种名:假结核耶尔森菌
拉丁学名:Yersinia pseudotuberculosis
分类学地位:细菌界Bacteria;变形菌门Proteobacteria;
γ-变形菌纲Gammaproteobacteria;肠杆菌目Enterobacteriales;
肠杆菌科Enterobacteriaceae;耶尔森氏菌属Yersinia
假结核耶尔森菌(Yersinia pseudotuberculosis)存在于多数动物的肠道中,形态和培养特性似小肠结肠炎耶尔森菌,能在患病动物的脏器中形成粟粒状的结核结节。人类主要通过食用被患病动物污染的食物而受感染,可在感染部位形成结核样肉芽肿。常发生于5-15岁的青少年,多表现为胃肠炎、肠系膜淋巴结肉芽肿或回肠末端炎等,偶尔会发展为败血症。
1.1生物学特性
1.1.1培养特征
假结核耶尔森菌可在巧克力琼脂、MacConkey琼脂(MAC)、羊血琼脂(SBA)等培养基上培养,最好的选择性培养基为CIN琼脂,特征性形成直径约1 mm“公牛眼”状菌落,中心呈深红色,而菌落最外周部分则无色透明的一环[1]。
图1 MAC琼脂培养基培养情况[2]
1.1.2形态学特征
假结核耶尔森菌是为卵圆形、短小的革兰氏染色阴性杆菌,需氧或兼性厌氧,生长温度较为宽泛,0-45℃均可生长,22-30℃生长最佳,在低温下仍然可以存活,低温存活6个月以上,生长环境pH 4.0-10.0,可以适应中强酸碱,在25℃以下培养时有周身鞭毛,表现出动力,但在37℃以上培养时鞭毛消失,无动力[3]。

图2 假结核耶尔森菌革兰氏染色阴性图[4](×1000)
1.1.3生化特征
假结核耶尔森菌氧化酶、硫化氢、枸橼酸盐、VP、吲哚酶以及亚硝酸盐等其他生化反应均阴性,脲酶、尿素阳性,能够发酵葡萄糖、甘露醇和李鼠糖,能水解七叶苷。通过棉子糖、蜜二糖、枸橼酸利用试验可分为4个生物型[5]。
1.2分布、传播与致病性
1.2.1分布与传播
假结核耶尔森菌分布非常广泛,从昆虫、鸟类到哺乳动物均可成为该菌的宿主。该菌广泛分布于各种水体及土壤等环境中,在各种清洁度的水源:井水、细菌学洁净的泉水、1级和2级清洁度的地表水以及严重污染的水体都曾分离[6]。
假结核耶尔森菌主要依靠粪-口途径传播,人类感染主要是通过接触被感染动物粪便污染的食物和水以及与动物的直接接触造成的。
1.2.2致病性
假结核耶尔森菌具有嗜淋巴组织的特征,也具有抵抗非特异性免疫反应的能力,尤其是抵抗巨噬细胞、多形核白细胞吞噬和杀灭的能力。其致病性是由染色体和一个70 kb的毒性大质粒(pYV)编码的毒力因子所决定的,virF、inv等基因也是重要的致病性菌株基因标志,它具有粘附性、侵袭性、对宿主细胞的干扰性及毒素作用。
假结核耶尔森菌感染机体进入消化道后,在肠粘膜通过小肠上皮细胞或者M细胞进入下层的淋巴组织(即Peyer结),这种侵袭作用导致大量的多核白细胞增生,并与细胞外耶尔森菌形成微小脓肿,最终导致Peyer结细胞结构的完全崩解。部分患者细菌向深部播散入血,移行到肝、脾等发生全身损害。假结核耶尔森菌除引起一系列肠道症状外,还引起一系列肠道外综合征,如肠系膜淋巴结炎、结节性红斑、关节炎、耶尔森肝炎等,严重者还可引起败血症[7]。
1.3检测方法
(1)传统方法:通常检测假结核耶尔森菌的方法为细胞培养观察培养特征或根据氧化酶试验、尿素酶试验、糖发酵试验等发酵实验的生化特性进行鉴定。
(2)免疫学方法:主要是血清凝集试验和免疫分析。最常见血清学检测是YOP-ELISA和基于YOP的免疫印迹检测;免疫分析主要是酶联免疫吸附试验(ELISA)、免疫荧光技术(IFA)和免疫层析技术(ICT),ELISA中吸光度值高于阈值,免疫荧光中可见特异性荧光,免疫层析中可见检测线和质控线都可说明存在该菌。
(3)分子生物学方法:常用DNA探针杂交或PCR法。例如:使用TaqMan实时荧光定量PCR法,设计引物与探针,配置PCR混合液而后在96孔板中进行PCR循环,并使用以下程序:在95℃下初始变性10分钟,然后在95℃下进行45个变性循环15秒,引物退火和延伸在60℃下1分钟[8]。
表1 假结核耶尔森菌TaqMan实时荧光定量PCR的引物序列、探针序列[8]
| 名称 | 序列 |
| 引物Yps1 | CGTCTGTTAATGTGTATGCCGAAG |
| 引物Yps2 | GAACCTATCACTCCCCAGTCATTATT |
| MGB探针 | NED-ATGCTCAAAGTCGTGTCAA-MGB |
| TAMRA探针 | VIC-CGTGTCAAGGACGATGGGTACAAGTTGG-TAMRA |
1.4典型案例
一名40岁的佛教僧侣因腹痛、发热、意识模糊入院,他有在寺庙饮用未经处理的山泉水的病史,入院前几天出现上述症状。在过去的病史中,他患有肝硬化。从他的血液和腹水中分离出假结核耶尔森氏菌;对他饮用的山泉水进行培养,同时分离出假结核耶尔森菌。血液,腹水,饮用水用PCR方法检测假结核菌inv基因和毒力质粒virF基因,所有菌株virF、inv基因均为阳性,自身凝集试验也呈阳性,所有这些证据都支持山泉水被假结核耶尔森氏菌污染,并且是感染源。此外,每个菌株都具有70 kb的毒力质粒,该毒力质粒是毒力所必需的,并且区分致病性和非致病性耶尔森氏菌[9]。
1.5防治对策
假结核耶尔森菌可通过污染的食品传播,因此要确保食品来源安全,避免食用未经充分加热处理的肉类、乳制品等;它也可通过水源传播,因此要确保饮用水的清洁,不喝生水或有可能被污染的水。养成饭前便后洗手的习惯,避免接触可能被污染的物品后再触摸口鼻。
参考文献
[1] 王鑫, 景怀琦. 假结核耶尔森菌研究进展. 中国人兽共患病学报, 2007, 10: 1041-1046.
[2] https://phil.cdc.gov/Details.aspx?pid=17247.
[3] 莎日娜, 赵良娟, 庞璐 等. PCR-核酸试纸条法检测食品中假结核耶尔森菌. 食品安全质量检测学报, 2018, 9: 6107-6111.
[4] Takehiro H, Ryuichi T, Haruka F et al. Septic shock due to Yersiniapseudotuberculosis infection in an adultimmunocompetent patient: a case report and literature review. BMC Infectious Diseases, 2021, 21: 36.
[5] 谢扬虎, 陈梅远. 眼分泌物标本检出假结核耶尔森菌1例. 临床检验杂志, 2015, 33: 560.
[6] JPekka N, Taina N, Saija H et al. A widespread outbreak of Yersinia pseudotuberculosis O: 3 infection from iceberg lettuce. The Journal of infectious diseases, 2004, 189: 766-774.
[7] 古文鹏, 景怀琦. 耶尔森菌致病机理研究. 中国人兽共患病学报, 2010, 26: 862-866.
[8] Lambertz S, Thisted N, Hallanvuo S et al. TaqMan-Based Real-Time PCR Method for Detection of Yersinia pseudotuberculosis in Food. Applied and Environemental Microbiology, 2008, 74: 6465-6469.
[9] Tae HH, In KP, Seong JK. Molecular Relatedness between Isolates Yersinia pseudotuberculosis from a Patient and an Isolate from Mountain Spring Water. Journal of Korean Medical Science, 2003, 18: 425.
.png)
